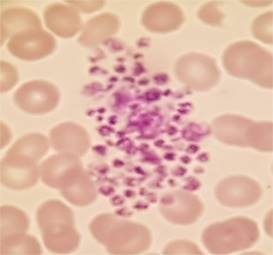

Platelet Clumping
Originally created January 2018. Last update 5 January 2021
Overview
I’ll take it as read that we all know what platelets are and what they
do…
Platelet counts in the reference
range don’t usually give us too much trouble in reporting, even if some
clumping is present, mainly because they are "normal". Adequate
platelet counts fall within a typical reference range of about 150- 450 x 103/μL.
If there are instrument flags for a
platelet abnormal scattergram or platelet clumps, repeat counting by another
method is advisable. Most initial platelet counts are performed by impedance
counting, but many analyzers can also count platelets by optical/fluorescent
techniques.
However all techniques have their
limitations
With impedance counting, very small
red cells and red cell fragments may be counted as platelets; giving a wrongly
increased platelet count.
With optical counting, large
platelets may be counted as red cells giving a falsely decreased count.
Some analyzers use impedance and
optical counts and also feature fluorescent platelet counts which use a
platelet specific dye thereby providing accurate platelet counts without the
interferences of other methods.
Given a
"normal" platelet count, even with clumping seen on a smear, all is clinically well. We have a
"normal" result.
Thrombocytopenia however is a
different matter. Given thrombocytopenia an accurate count is vital to
diagnose, treat and monitor patients. Even a small increase or decrease can be
significant when there is a severe thrombocytopenia. With fewer platelets,
every platelet counts!
It can be dangerous to miss true
thrombocytopenia but is also dangerous to report a low platelet count in a
patient with a spurious thrombocytopenia who is not actually thrombocytopenic.
One of the first questions we must
ask with an apparent thrombocytopenia is if this is a true thrombocytopenia or
not. A true thrombocytopenia represents a patient with a low platelet count who
may need monitoring or medical intervention. A false one does not, and should
not be treated as such
So... with this in mind
I had this case a couple of years ago


Look at that platelet count. Half of what
it has been previously. Microscopy revealed why. That result wasn’t correct.
The platelet count wasn’t reduced at all; because the platelets were clumped
the analyser wasn’t able to count them. Platelet clumping causes a falsely
decreased automated platelet count and so in such a case no result can be
issued for a platelet count.

That result of 83 was wrong. The
platelet count wasn’t reduced at all; because the platelets were clumped the
analyser wasn’t able to count them. Platelet clumping causes a falsely
decreased automated platelet count and so in such a case no result can be
issued for a platelet count.
Platelet clumping is a relatively common
laboratory finding. In my experience I see it on a daily basis.
It can have a range of causes:
It is commonly caused by platelet
activation due to traumatic venepuncture. Such instances are transient,
subsequent samples giving reliable platelet counts.
Another common cause is underfilling or
overfilling of sample bottles leading to partially clotted samples.
It can also be caused by
cold-reacting autoantibodies.
It is less commonly caused by
EDTA-dependent antibodies that react with platelet glycoprotein
IIb/IIIa.
Other reported causes include
multiple myeloma, infections, anticardiolipin antibodies, high immunoglobulin
levels, abciximab therapy.
So…. How do we do resolve the issue to be able to issue a reliable
platelet count?

Given a previous result in the
reference range a correctly filled repeat sample taken without excessive trauma
and brought directly to the laboratory without delay may well resolve the
issue.
As is the case with red cell
autoagglutination warming the sample can reverse the clumping *if*
cold-acting antibodies is the cause.
Clumping can be corrected by using
blood collection tubes containing an alternative anticoagulant such as sodium
citrate or lithium heparin... or so some of the literature claims. Other reports
claim that many of the antibodies which cause clumping in EDTA do so in other
anitcoagulants.
It is claimed (by some) that platelet clumps can be disrupted by
vortex mixing… my gut reaction to that is “OMG”... but clearly others
have had success at this. Just maybe I’ll get out a vortex mixer and
experiment?
Some More Expert Opinion…
Lixia Zhang, MMed,* Jian Xu, MD,* Li
Gao, MMed, Shiyang Pan, MD, PhD. Spurious Thrombocytopenia in Automated
Platelet Count. Laboratory Medicine 49:2:130-133. 2018
Manthorpe R, Kofod B, et al.
Pseudothrombocytopenia, In vitro studies on the underlying mechanisms.
Scand J Haematol 1981; 26:385-92
Schuff-Werner,Peter, et al. Effective
estimation of correct platelet counts in pseudothrombocytopenia using an
alternative anticoagulant based on magnesium salt. Brit J of Haematol Vol
162, Issue 5. June 29, 2013
Tan, Geok Chin et al. Pseudothrombocytopenia
due to platelet clumping: A Case Report and Brief Review of the Literature.
Case Reports in Hematology. Volume 2016